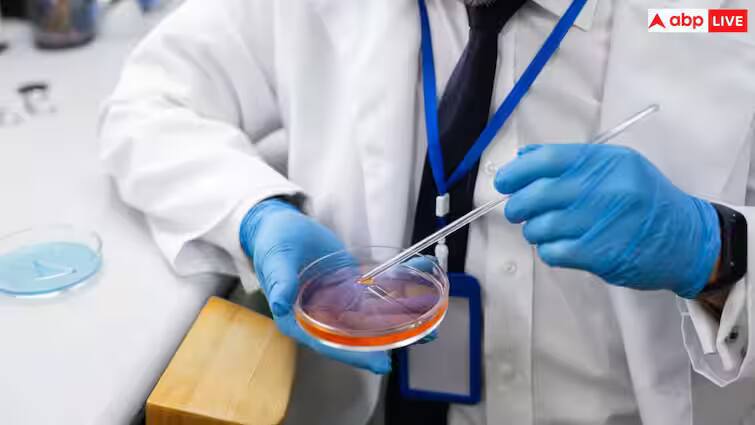
lifestyle: હવે તમે કોઈપણ ઉંમરે બની શકશો માતાપિતા, લેબમાં બનશે સ્પર્મ અને એગ્સ scientists-are-close-to-developing-in-vitro-gametogenesis-ivg-to-create-eggs-and-sperm-in-labs lifestyle: હવે તમે કોઈપણ ઉંમરે બની શકશો માતાપિતા, લેબમાં બનશે સ્પર્મ અને એગ્સ

lifestyle: હવે તમે કોઈપણ ઉંમરે બની શકશો માતાપિતા, લેબમાં બનશે સ્પર્મ અને એગ્સ
lifestyle: એક બ્રિટિશ વૈજ્ઞાનિકે દાવો કર્યો છે કે તેઓ ટૂંક સમયમાં તેમની લેબમાં શુક્રાણુ અને ઇંડા(eggs) ઉત્પન્ન કરવા માટેની ટેકનોલોજી વિકસાવવા જઈ રહ્યા છે. હવે આ દ્વારા કોઈપણ દંપતી માતા પિતા બની શકશે.
lifestyle: બાળક પેદા કરવા માટે, સ્ત્રી અને પુરુષ બંનેની પ્રજનન પ્રણાલી (Reproductive System) જરૂરી છે. જેમ તમે જાણો છો, જ્યારે પુરુષના શુક્રાણુ સ્ત્રીના ઇંડાને મળે છે, ત્યારે ગર્ભ બને છે. પરંતુ આજકાલ, ખરાબ જીવનશૈલી અને ખાવાની આદતોની સીધી અસર પુરુષો અને સ્ત્રીઓની પ્રજનન ક્ષમતા પર પડે છે. બ્રિટનના હ્યુમન ફર્ટિલાઇઝેશન એન્ડ એમ્બ્રાયોલોજી ઓથોરિટી (HFEA) ના એક અહેવાલ મુજબ, હવે લેબમાં સરળતાથી ઇંડા અને શુક્રાણુ બનાવવા માટે ટેકનોલોજી વિકસાવવામાં આવી રહી છે. જેના દ્વારા, આગામી 10 વર્ષમાં, લેબમાં સરળતાથી શુક્રાણુ અને ઇંડા બનાવીને બાળકો પેદા કરવામાં આવશે.
ઇન-વિટ્રો ગેમેટ્સ (IVGs)
બ્રિટિશ વેબસાઇટ ધ ગાર્ડિયનના અહેવાલ મુજબ, લેબમાં ઇંડા અને શુક્રાણુ બંને સરળતાથી બનાવી શકાય છે. જેને ઇન-વિટ્રો ગેમેટ્સ (IVGs) કહેવામાં આવે છે. આમાં, ત્વચા અને સ્ટેમ સેલ દ્વારા ઇંડા અને શુક્રાણુ દ્વારા ઇંડા બનાવવામાં આવશે. આગામી 10 વર્ષમાં તેનો સંપૂર્ણ વિકાસ થશે. આમાં, યુગલો કોઈપણ ઉંમરે માતાપિતા બનવાનું સુખ માણી શકે છે. આ ટેકનોલોજી દ્વારા, સિંગલ લોકો અને ગે યુગલો માતાપિતા બની શકે છે. આ દુનિયામાં એક ખાસ પરિવર્તન લાવી શકે છે.
પુરુષો અને સ્ત્રીઓને ઉંમર વધવાની સાથે પ્રજનન સમસ્યાઓનો સામનો કરવો પડે છે. ઇંડા અને શુક્રાણુઓમાં ઘટાડો થાય છે. આનાથી, વધુને વધુ લોકો પ્રજનનક્ષમતાની સારવાર મેળવી શકે છે. આનાથી સોલો પેરેન્ટિંગ અને મલ્ટિપ્લેક્સ પેરેન્ટિંગ જેવા રસ્તા ખુલી શકે છે. સોલો પેરેન્ટિંગનો અર્થ એ છે કે વ્યક્તિ પોતાના ઇંડા અને શુક્રાણુઓથી બાળક પેદા કરી શકશે.
મલ્ટિપ્લેક્સ પેરેન્ટિંગમાં, બે યુગલો ઘણીવાર એકસાથે બે ગર્ભ બનાવે છે. પછી પ્રયોગશાળામાં આ ભ્રૂણમાંથી ઇંડા અને શુક્રાણુ તૈયાર કરવામાં આવશે. જેથી તેમાંથી બીજો નવો ગર્ભ બનાવી શકાય. આનાથી આનુવંશિક રોગોનું જોખમ ઓછું થાય છે. જોકે, આના દ્વારા લેબમાં મોટી સંખ્યામાં ભ્રુણ બનવાની શક્યતા છે. પરંતુ તેની સાથે એક જોખમ સંકળાયેલું છે, જેમ ગર્ભાવસ્થા દરમિયાન જોખમ હોય છે. આ કારણે, વૃદ્ધાવસ્થામાં પણ બાળકોનો જન્મ થઈ શકે છે.
HFEA માને છે કે સંભવિત દુરુપયોગને રોકવા માટે પ્રશ્નમાં રહેલી ટેકનોલોજી લાગુ કરવામાં આવે તે પહેલાં કાનૂની અને નૈતિક નિયમન જરૂરી છે. તેણે આ ટેકનિક પર વધુ સંશોધન કરવાની ભલામણ કરી અને સ્પષ્ટતા કરી કે ઇન વિટ્રો ગેમેટોજેનેસિસ (IVG) હાલમાં તબીબી સારવાર તરીકે ઉપલબ્ધ નથી. જો કે, ભવિષ્યમાં આ ટેકનિક પ્રજનન સારવારનો નિયમિત ભાગ બની શકે છે. આ પ્રગતિ માટે કાયદામાં ફેરફારની જરૂર પડશે. એક એવો નિર્ણય જે બ્રિટિશ સંસદ પર નિર્ભર છે.
Disclaimer: સમાચારમાં આપવામાં આવેલી કેટલીક માહિતી મીડિયા રિપોર્ટ્સ પર આધારિત છે. કોઈપણ સૂચનનો અમલ કરતા પહેલા, તમારે સંબંધિત નિષ્ણાતની સલાહ લેવી જોઈએ.
Check out below Health Tools-
Calculate Your Body Mass Index ( BMI )





















